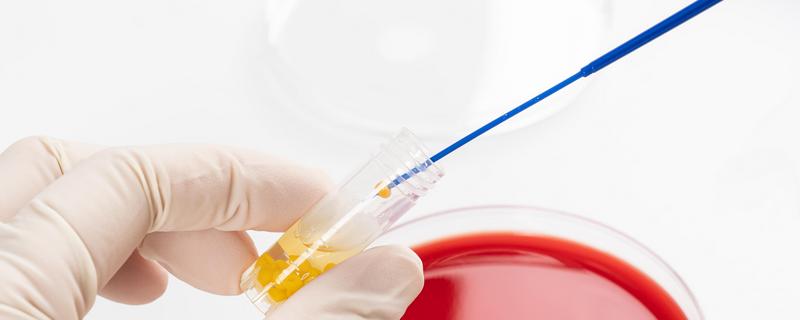
菌种传代的操作规程,菌种管在前接种管在后

自然发酵:将鸡粪平铺于阳光直射处,晒干后建堆并覆膜,待堆温升高至70℃时撤膜并摊开降温,待温度下降至50℃后继续堆积覆膜,如此重复...
叶片形态:重瓣铁线莲的叶片呈狭卵形、披针形,而转子莲的叶片相对较小、呈菱形的且有黄长毛。花期:重瓣铁线莲的花期为每年的1-2月份,...
垂钓小型翘嘴鱼,深度保持在2米以内。垂钓大型翘嘴鱼,深度为2-3米。如果水温较低,翘嘴鱼会进入深水区避寒,此时要钓深。冬季垂钓,可...
进行修剪:使用消毒的锋利剪刀剪去过密枝叶及过长枝叶、病害枝叶、干枯发黄枝叶。科学施肥:生长期间定期追施氮肥,花期前后叶面喷施磷酸二...
养殖白掌应使用适中的深盆,花盆规格因植株大小而异,如果盆大苗小,则会影响根系伸展,而且容易因透气性差而引发烂根。养殖白掌适合使用透...
土壤:以排水良好的偏碱性沙质土壤为宜。光照:夏季定植后适当遮阴,缓苗后逐渐见光。夏季中午时分需遮光,傍晚时分浇足水。浇水:根据土壤...
桃树上面的桃胶不可以直接食用。原因:桃树上的桃胶未经过浸泡、蒸、干燥、加工等处理,其中含有一定杂质以及细菌,食用后可能会导致人体不...
点燃酒精灯,于火焰旁上方灼烧接种环。夹住菌种管和接种管,然后斜持试管45°,让试管内斜面向上,两个试管口平齐。右手在火焰旁边转动两...
枸杞:生性耐寒,种子发芽温度为7℃左右,幼苗能忍耐-3℃低温。降温至-25℃时,不会发生冻害。生性抗旱,可适应沙漠环境,但花果期要...
叶片比较长的植物有兰花、绿萝、龟背竹、发财树、落地生根等。兰花:兰花叶片较长,平时应当置于采光良好处养护。绿萝:绿萝叶片较大,耐阴...
外表颜色:果实发黑,外表腐烂,产生黑色斑点。果肉:颜色发黄,质软,腐烂部位出现白色菌状物。气味:腐烂的果实,会散发出刺鼻的异味。在...
土壤:使用培养土、粗砂、泥炭土混合配制盆土,并往土壤中施加少量有机肥。光照:养护期间,每天提供8小时以上的光照,光照以柔光或散射光...
野生甲鱼:从幼苗到成年需要3-5年,增重量只有100克左右/年。野生甲鱼需自行摄食,且野外环境差,所以生长速度慢。人工养殖的甲鱼:...
鲶鱼的鳞片已经退化,因此鲶鱼通常被划分至无鳞鱼一类。鱼类的鱼鳞主要起到保护鱼体、避免细菌及有害物质入侵的作用。而鲶鱼虽然没有鱼鳞,...
选择土壤:盆土选择排水透气良好、富含有机质的沙壤土或腐殖土,养护过程中定期松土。提供水分:养护期间需定期浇水,土壤以保持湿润为宜。...
泥鳅有细小鳞片,但是并不明显,因此通常将其划分至无鳞鱼一类。泥鳅体表覆有较多粘液,并且鳞片极其细小,因此摸起来十分滑溜。泥鳅的鳞片...
从母株上剪取生长健壮、长约10cm的枝条,修剪后对母株以及枝条伤口进行消毒。剪去枝条底部的叶片,仅保留顶端2-4片叶,然后置于多菌...